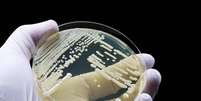
Candida auris é resistente às medicações usadas para combater fungos do mesmo gênero  Foto: TopMicrobialStock

Pernambuco confirma três casos de superfungo em hospital no Recife
Um paciente permanece internado; outros dois morreram em decorrência das doenças de base
Pernambuco confirmou três casos do superfungo Candida auris em um hospital no Recife; dois pacientes faleceram devido a doenças de base e um permanece internado em estado estável.
A Secretaria Estadual de Saúde (SES-PE) informa ter confirmado três casos do fungo Candida auris (E. auris) no Hospital Otávio de Freitas (HOF), no Recife. Três pacientes, homens de 33, 44 e 49 anos de idade, tiveram resultado laborial positivo para a presença do superfungo.
Receba as principais notícias direto no WhatsApp! Inscreva-se no canal do Terra
Segundo a pasta, eles tinham histórico de tratamento de algumas doenças de base — ou seja, doenças prévias que podem agravar a condição da infecção pelo fungo —, como AVC, câncer e tuberculose.
Apenas um deles, o de 33 anos, permanece internado, em isolamento, na Unidade de Terapia Intensiva respiratória do hospital, com quadro de saúde considerado estável. Já os outros dois pacientes, de 44 e 49 anos, vieram a óbito em decorrência das doenças de base.
Por causa dos diagnósticos positivos para Candida auris, a direção da unidade suspendeu novas admissões na UTI onde o paciente está internado. Já as visitas seguem liberadas, porém com o número restrito de visitantes.
A SES afirma que a suspensão das admissões no setor possibilitará que sejam realizadas todas as medidas de limpeza e desinfecção de superfícies, além do monitoramento dos pacientes a fim de evitar o surgimento de novos casos.
O que é o superfungo?
O fugo Candida auris apresenta a possibilidade de causar infecções invasivas e associadas à alta mortalidade, quando em pacientes que estão em condição de baixa imunidade.
Junto a outras três espécies (uma do mesmo gênero, o Candida albicans, conhecida por causar candidíase genital e "sapinho"), o Candida auris está na lista de fungos que apresentam risco à saúde pública, segundo a Organização Mundial da Saúde (OMS). A infecção oportunista e invasiva causada por ele atinge principalmente pacientes imunossuprimidos (como pacientes oncológicos, transplantados e com HIV) e acamados em hospital por longos períodos.
O primeiro caso de Candida auris no Brasil foi registrado em 2020, no contexto da pandemia de covid-19. Desde então, outros surtos foram noticiados, mas que foram contidos rapidamente.

-sksc2lw2f7fq.jpg)






-skyebybkch14.jpg)













Comentários
Os comentários são de responsabilidade exclusiva de seus autores e não representam a opinião deste site. Se achar algo que viole os termos de uso, denuncie.